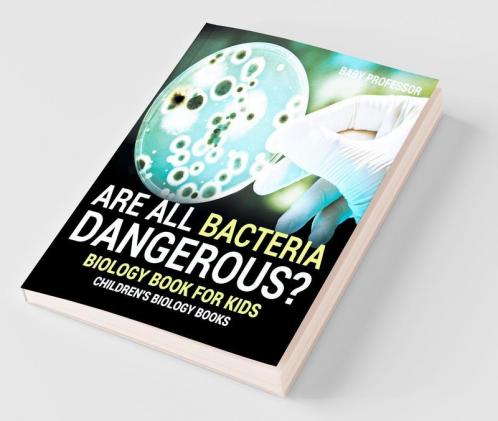
Are All Bacteria Dangerous? Biology Book for Kids | Children's Biology Books
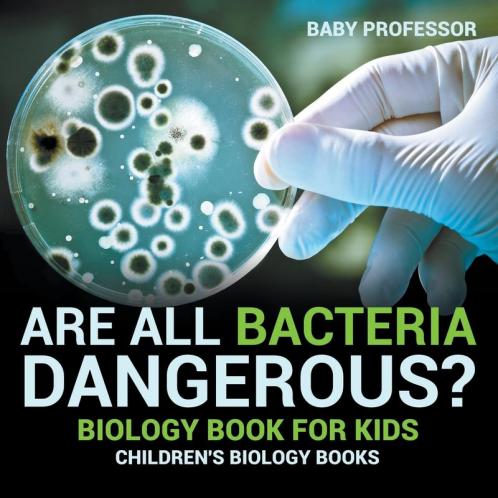
Are All Bacteria Dangerous? Biology Book for Kids | Children's Biology Books

This Book is Out of Stock!
English
Paperback
₹1226
₹1585
22.65% OFF
(All inclusive*)
Delivery Options
*COD & Shipping Charges may apply on certain items.
Review final details at checkout.
Looking to place a bulk order? SUBMIT DETAILS
About The Book
Description
Author
If you're child is into science or you would like him/her to be then this biology book is a must-have! Bacteria is always all around us but that doesn't mean we should be perpetually afraid of them. Lack of knowledge on the subject will make you fear too much. That is why it is important to encourage your child to pick up the habit of reading.
*COD & Shipping Charges may apply on certain items.
Review final details at checkout.
₹1226
₹1585
22% OFF
Paperback
Out Of Stock
All inclusive*
Details
ISBN 13
9781541910706
Publication Date
-15-03-2017
Pages
-64
Weight
-135 grams
Dimensions
-216x216x3.89 mm